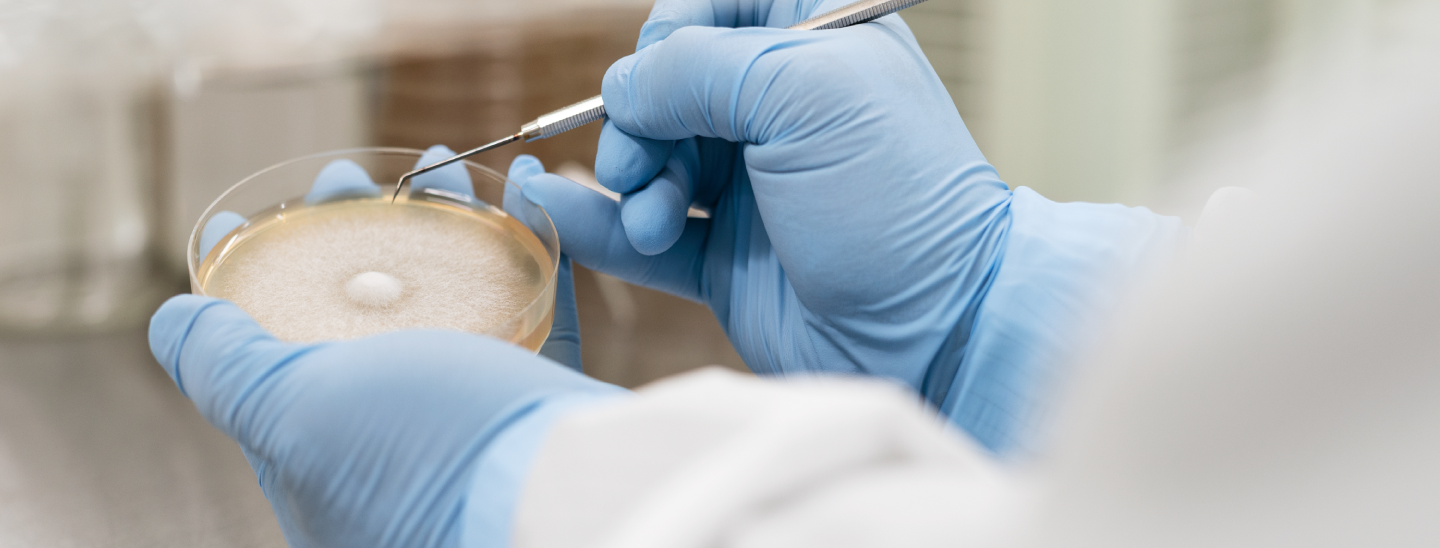
スライド

おいしく、健康的な
食生活のために
昭和48年、創業者である加藤忠芳が
ミカン生産から
えのき生産に事業を切り替えたのが
加藤えのきの始まりです。
過去には2度の水害に見舞われながらも、
多くの人々の支え
により、
西日本最大級のえのき生産企業となりました。
これからも「おいしさ」と「健康」をテーマに、
関わる人々の笑顔を大切にし、
全国の皆様に愛される企業を目指してまいります。
株式会社 加藤えのき
代表取締役
加藤修一郎

おいしく、健康的な
食生活のために
昭和48年、創業者である加藤忠芳が
ミカン生産から
えのき生産に事業を切り替えたのが
加藤えのきの始まりです。
過去には2度の水害に見舞われながらも、
多くの人々の支え
により、
西日本最大級のえのき生産企業となりました。
これからも「おいしさ」と「健康」をテーマに、
関わる人々の笑顔を大切にし、
全国の皆様に愛される企業を目指してまいります。
株式会社 加藤えのき
代表取締役
加藤修一郎




詳細はこちら